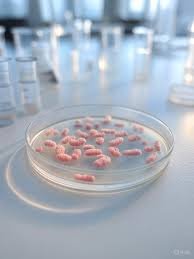
Northwestern University Uncovers Lyme Disease’s Surprising Weakness: A Breakthrough in Treatment

Alex Singleton’s Courageous Battle: Broncos Linebacker Undergoes Successful Testicular Cancer Surgery
The NFL community and fans globally are rallying behind Denver Broncos linebacker Alex Singleton, who recently underwent successful surgery for testicular cancer. The news, confirmed by the Broncos organization, highlights not only the athlete’s resilience but also underscores the critical importance of early detection in the fight against cancer. Singleton, 31, is currently recovering, with team doctors expressing confidence in his return to the field.
A Champion’s Fight Off the Field: Alex Singleton’s Journey
The diagnosis for Alex Singleton emerged last week following a routine, random drug test that flagged indicators prompting further health investigations. Swift action led to a diagnosis of testicular cancer, and Singleton underwent successful surgery last Friday. The Denver Broncos released a statement emphasizing their priority:
“Our No. 1 priority is Alex’s health and well-being, and we are grateful it appears the cancer was caught early. Alex and his family have our unwavering support as we look forward to welcoming him back on the field soon.”
This swift medical response and the team’s transparent communication offer a beacon of hope, reminding us that even in unexpected circumstances, timely intervention can make all the difference for someone like Alex Singleton.
The Critical Role of Early Detection in Cancer Survival
Singleton’s case serves as a powerful reminder of why early detection is paramount. The initial flagging by a drug test, while unconventional, proved to be life-saving. Testicular cancer, when diagnosed and treated in its early stages before it spreads to vital organs, boasts an exceptionally high survival rate. According to the American Cancer Society, the survival rate ranges from 95% to 99%.
This statistic offers immense hope for Alex Singleton and countless others. It also highlights the need for regular self-examinations and routine health checks, even for seemingly healthy individuals like professional athletes.
Understanding Testicular Cancer: Key Facts for Men’s Health
While the news about Alex Singleton is a personal challenge, it also brings crucial awareness to testicular cancer, a disease often overlooked but prevalent among younger men. Here are some vital facts:
- Prevalence: It is most common among men aged 15 to 34, though it can occur at any age.
- Incidence: Approximately 1 in 250 men will develop testicular cancer in their lifetime.
- Mortality: While serious, early detection significantly reduces fatalities. Around 600 people die from it each year in the U.S.
- Symptoms: Common symptoms include a lump or enlargement in either testicle, a feeling of heaviness in the scrotum, a dull ache in the abdomen or groin, or sudden collection of fluid in the scrotum.
Resources like Testicular Cancer Awareness Month emphasize proactive health management and education.
Unwavering Support for the Broncos Linebacker
Alex Singleton, a native of Thousand Oaks, California, is in his fourth season with the Denver Broncos, having previously played three years with the Philadelphia Eagles. Throughout his career, he has been a consistent presence on the field, and now, he faces his biggest challenge yet. The unwavering support from his team, family, and the broader NFL community will undoubtedly be a cornerstone of his recovery.
The focus now shifts to Singleton’s full recovery and a hopeful return to the gridiron. While the timeline is still being determined by additional test results, the initial prognosis is overwhelmingly positive, showcasing the power of medical science and personal fortitude.
A Call for Awareness and Action
The story of Alex Singleton is more than just a sports headline; it’s a powerful narrative about health, resilience, and the life-saving impact of early detection. We wish Alex a swift and complete recovery and hope his journey inspires men everywhere to prioritize their health and seek medical attention when needed. His courage off the field is as remarkable as his performance on it.